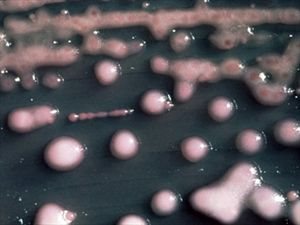

|
Manos Manos |
Σάββατο, 2 Αυγούστου 2014 |
|
|
|
"Βακτήρια - εφιάλτης" εξαπλώνονται στις ΗΠΑ
Φονικά και σχεδόν μη ιάσιμα σούπερ - βακτήρια με το όνομα CRE ή αλλιώς "βακτήρια - εφιάλτες" έχουν εξαπλωθεί σε ανησυχητικό βαθμό στα βορειοανατολικά των ΗΠΑ, τα τελευταία χρόνια, σύμφωνα με έρευνα που βλέπει τώρα το φως της δημοσιότητας.
Σύμφωνα με το Russia Today ερευνητές στο Duke University Medical Center εντόπισαν περιπτώσεις τέτοιων βακτηρίων που είναι ανθεκτικά στην αντιβίωση, να έχουνπολλαπλασιαστεί στα νοσοκομεία της περιοχής από το 2008 ως το 2012.
"Προσπαθούμε να κρούσουμε τον κώδωνα του κινδύνου. Αυτό είναι ένα πρόβλημα για όλους όσους εργάζονται στις υπηρεσίες Υγείας" δήλωσε ο Deverick J. Anderson, ο οποίος ηγείται της ομάδας που διεξάγει την έρευνα και επισκέπτης καθηγητής Ιατρικής στο Duke.
Τα βακτήρια CRE ζουν στο έντερο των ανθρώπων, συχνά χωρίς να προκαλούν ασθένεια, ωστόσο όταν "δραπετεύουν" από το περιβάλλον τους, μπορούν να προκαλέσουν μολύνσεις, ειδικά στους πιο αδύναμους και καταπονημένους οργανισμούς - γι' αυτό "θριαμβεύουν" στα νοσοκομεία.
nooz
|
|
|
 | Ανάγνωση… |
  
 | Ανάγνωση… |
|